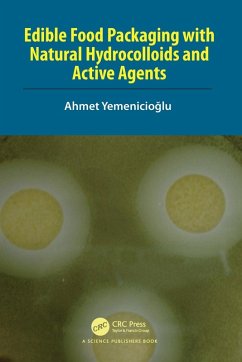

Edible Insects Processing for Food and Feed
From Startups to Mass Production
Herausgeber: Grasso, Simona; Bordiga, Matteo
Versandkostenfrei!
Versandfertig in 1-2 Wochen
106,99 €
inkl. MwSt.
Weitere Ausgaben:

PAYBACK Punkte
53 °P sammeln!
This book aims to bring together the latest advancements in edible insect production. It gives readers a flavour of where the fascinating topic of edible insect production is now, but more importantly of where it might be heading to in the future, showcasing several related challenges and opportunities.